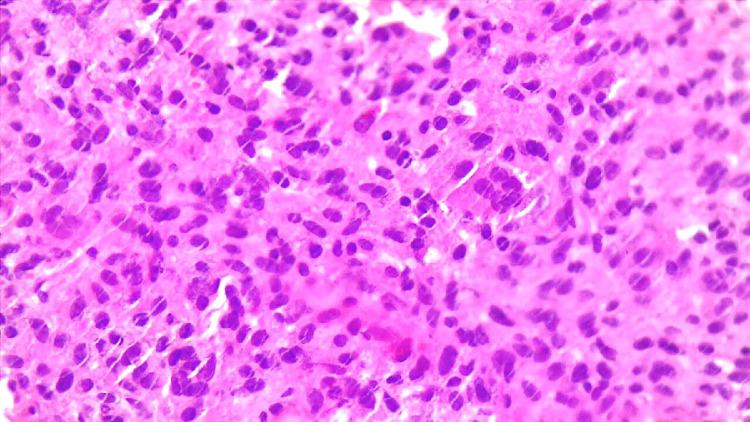
https://cdn.ncbi.nlm.nih.gov/pmc/blobs/40c7/10789933/0c4a82dd0edb/gr3.jpg

一例酷似动静脉畸形的骨巨细胞瘤肺转移病例报告
A case report on pulmonary metastasis of giant cell tumor mimicking arteriovenous malformation.
作者信息
Yazdi Niloofar Ayoobi, Parviz Sara, Delazar Sina, Azadnajafabad Sina, Aleseidi Samira, Saffar Hana, Sadighi Nahid
机构信息
Department of Radiology, School of Medicine, Advanced Diagnostic and Interventional Radiology Research Center (ADIR), Imam Khomeini Hospital complex (IKHC), Tehran University of Medical Sciences, Tehran, Iran.
Heumatology and Internal Medicine, Rheumatology Research Center, Tehran University of Medical Sciences, Tehran, Iran.
出版信息
Radiol Case Rep. 2023 Dec 28;19(3):1078-1082. doi: 10.1016/j.radcr.2023.11.075. eCollection 2024 Mar.
Giant cell tumor (GCT) is typically a benign tumor of the skeletal system that mainly presents with bone pain. Pulmonary metastasis is one of the distant presentations of GCT in patients who have previously undergone surgical resection of the tumor. Among the various presentations of pulmonary metastasis in GCT, lesions with arteriovenous malformation (AVM) features are rare and have only been reported in a few cases. In this case report, we present the case of a 29-year-old female patient who had previously undergone surgical resection of a GCT in her right lower extremity 4 years ago. The patient was referred to us with progressive dyspnea, and a lesion resembling an AVM was found during radiologic evaluation using chest computed tomography. Pathologic evaluation of the lesion after biopsy revealed that it was a metastasis of GCT presenting with vascular-like features in the lung. This study reports on a very rare occurrence of GCT pulmonary metastasis with an AVM appearance on imaging, highlighting the clinical importance of atypical presentations of pulmonary metastasis in patients with a history of GCT. Appropriate and timely screening and management of such lesions may prevent adverse outcomes such as massive hemorrhage and deterioration of lung function.
骨巨细胞瘤(GCT)通常是一种骨骼系统的良性肿瘤,主要表现为骨痛。肺转移是既往接受过肿瘤手术切除的GCT患者的远处表现之一。在GCT肺转移的各种表现中,具有动静脉畸形(AVM)特征的病变罕见,仅在少数病例中有报道。在本病例报告中,我们介绍了一名29岁女性患者的病例,该患者4年前曾接受右下肢GCT手术切除。患者因进行性呼吸困难转诊至我院,在胸部计算机断层扫描的影像学评估中发现了一个类似AVM的病变。活检后对病变进行病理评估显示,这是一个GCT肺转移灶,在肺内呈现出血管样特征。本研究报告了GCT肺转移在影像学上呈现AVM表现这一极为罕见的情况,强调了有GCT病史患者肺转移非典型表现的临床重要性。对此类病变进行适当及时的筛查和管理可预防大出血和肺功能恶化等不良后果。